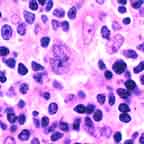

Go to:

TOC
|
Lymphocyte Predominance Hodgkin Lymphoma

This low power shot shows the vaguely nodular architecture. At this magnification the pattern might be confused with a small-cleaved follicular center cell lymphoma.

Though hard to discern its outline, a single nodule almost fills this picture. The large, paler cells in the midst of the small lymphocytes are either the neoplastic "L & H" cell variants of Reed-Sternberg cells or epithelioid histiocytes.


This shows at increasing magnification the L & H (lymphoid and histiocytic) cell. It has a polylobated nucleus. Unlike the classic Reed-Sternberg cell, nucleoli are neither markedly prominent nor cherry red, and no space cleared of chromatin surrounds them.

Table of Contents 
|